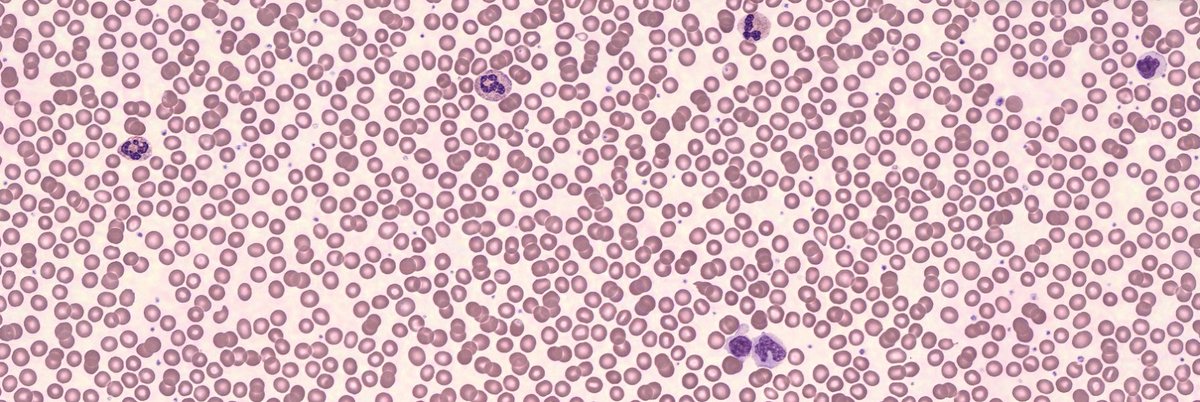

⬇️ انخفاضه
فقر الدم بسبب نقص الحديد بعض المرضى يكون عندهم مشكله في امتصاص الحديد فيضطرون ياخذون ابر للتعويض النقص
اللوكيميا والروماتيزم وتليف الكبد وبعض الادوية كمان مثل العلاج الكيماوي وفيه أسباب كثيرة بعد بس هذي الي تمر علي وانا اشتغل
فقر الدم بسبب نقص الحديد بعض المرضى يكون عندهم مشكله في امتصاص الحديد فيضطرون ياخذون ابر للتعويض النقص
اللوكيميا والروماتيزم وتليف الكبد وبعض الادوية كمان مثل العلاج الكيماوي وفيه أسباب كثيرة بعد بس هذي الي تمر علي وانا اشتغل
إذا طلع ناقص جدًا عن النتائج السابقه للمريض تكون PANIC VALU ونسجلها
وبعد نقطه مهمه لازم نتأكد من العينة نفسها لو كان فيها clotted اسوي rejected للعينة🤚🏻 ولو ماطلع فيه اسويها في جهاز ثاني عشان اتأكد ان البيشنت فعلًا الHemoglobin عنده منخفض واسجلها ✍🏻
وبعد نقطه مهمه لازم نتأكد من العينة نفسها لو كان فيها clotted اسوي rejected للعينة🤚🏻 ولو ماطلع فيه اسويها في جهاز ثاني عشان اتأكد ان البيشنت فعلًا الHemoglobin عنده منخفض واسجلها ✍🏻
Primary thrombocytosis :-
Essential thrombocytosis
Chronic myeloid leukemia
Polycythemia vera
Myelofibrosis-myelodysplastic syndromes
Essential thrombocytosis
Chronic myeloid leukemia
Polycythemia vera
Myelofibrosis-myelodysplastic syndromes
Secondary or reactive thrombocytosis :-
Infections
Inflammatory disorders
Acute or chronic blood loss
Tissue damage from trauma or surgery
Drugs (steroids, vincristine)
Hyperadrenocorticism
Splenectomy
Malignancy
Rebound from chemotherapy
Infections
Inflammatory disorders
Acute or chronic blood loss
Tissue damage from trauma or surgery
Drugs (steroids, vincristine)
Hyperadrenocorticism
Splenectomy
Malignancy
Rebound from chemotherapy
thrombocytopenia انخفاضها ⬇️
increased destruction
• Immune mechanism
/ lodopathic (ITP)
Secodary to infection, drugs, SLE
Non-immune mechanism
- platelet consumption , DIC
microangiopathie hemolytic
anemia
- platelet destruction ,Hypersplenism, drugs
increased destruction
• Immune mechanism
/ lodopathic (ITP)
Secodary to infection, drugs, SLE
Non-immune mechanism
- platelet consumption , DIC
microangiopathie hemolytic
anemia
- platelet destruction ,Hypersplenism, drugs
Decreased production
~ Bone marrow depression
- Hereditary
• Fanconi anemia
• TAR syndrome
- Acquired
Drugs, chemotherapy, Inefction, hepatitis ,HIV , EBV
~ Bone marrow infiltration
Leukemia ‚neuroblastoma , Storage disease
~ Bone marrow depression
- Hereditary
• Fanconi anemia
• TAR syndrome
- Acquired
Drugs, chemotherapy, Inefction, hepatitis ,HIV , EBV
~ Bone marrow infiltration
Leukemia ‚neuroblastoma , Storage disease
كمان لو حصل وكانت🔴 PANIC VALUE
أتأكد لو فيها clot ارفضها واذا مافيه أعيدها بجهاز ثاني وأسجلها ✍🏻
أتأكد لو فيها clot ارفضها واذا مافيه أعيدها بجهاز ثاني وأسجلها ✍🏻
WBC ⬇️ Leukopenia
Infection including bacterial or viral, chemotherapy, other medications (anti-epileptics, penicillins sulfonamides, cephalosporins thiazides, cimetidine, ethanol immunosuppressants) hematologic malignancy, aplastic anemia, hypersplenism, auto-immune disorders
Infection including bacterial or viral, chemotherapy, other medications (anti-epileptics, penicillins sulfonamides, cephalosporins thiazides, cimetidine, ethanol immunosuppressants) hematologic malignancy, aplastic anemia, hypersplenism, auto-immune disorders
جاري تحميل الاقتراحات...